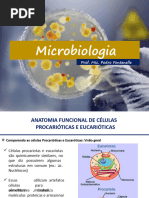

0% acharam este documento útil (0 voto)
99 visualizações38 páginasClassificação de Microrganismos e Tipos
O documento discute a classificação e taxonomia de microrganismos. Ele explica que existem três domínios de seres vivos de acordo com Woese: Archaea, Bacteria e Eukarya. Dentro destes domínios, existem reinos como Monera, Protista e Fungi. O documento também descreve as principais características morfológicas e estruturais de bactérias, fungos, protozoários e algas.
Enviado por
Ana Rita RibeiroDireitos autorais
© © All Rights Reserved
Levamos muito a sério os direitos de conteúdo. Se você suspeita que este conteúdo é seu, reivindique-o aqui.
Formatos disponíveis
Baixe no formato PPT, PDF, TXT ou leia on-line no Scribd
0% acharam este documento útil (0 voto)
99 visualizações38 páginasClassificação de Microrganismos e Tipos
O documento discute a classificação e taxonomia de microrganismos. Ele explica que existem três domínios de seres vivos de acordo com Woese: Archaea, Bacteria e Eukarya. Dentro destes domínios, existem reinos como Monera, Protista e Fungi. O documento também descreve as principais características morfológicas e estruturais de bactérias, fungos, protozoários e algas.
Enviado por
Ana Rita RibeiroDireitos autorais
© © All Rights Reserved
Levamos muito a sério os direitos de conteúdo. Se você suspeita que este conteúdo é seu, reivindique-o aqui.
Formatos disponíveis
Baixe no formato PPT, PDF, TXT ou leia on-line no Scribd